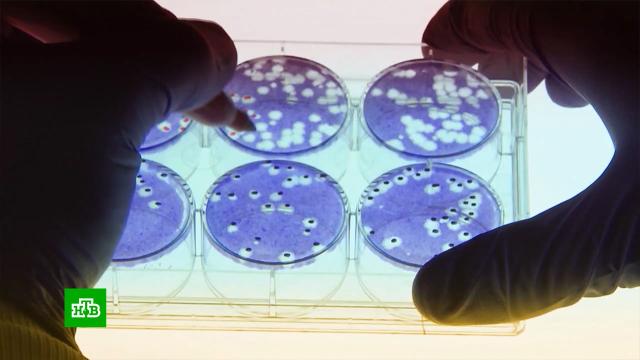

Новые данные об американской военно-биологической программе, возможно, прольют свет на многие вирусологические загадки последнего времени. Не исключено, что они удивят неожиданными подробностями того, насколько США продвинулись в создании и распространении смертельно опасных заболеваний.
Пентагон отрицает, что созданные на его деньги украинские биолаборатории занимались разработкой биологического оружия. Но документы, попавшие в распоряжение Минобороны России, доказывают обратное.
Российские специалисты войск радиационной, химической и биологической защиты выяснили, что в этих лабораториях на Украине, в частности, изучались возможности скрытого распространения опасных патогенов летучими мышами и перелетными птицами. В них проводились эксперименты с возбудителями сибирской язвы и африканской чумы свиней.
Документально подтвердилось, что эти исследования велись при участии американских специалистов, хотя власти США утверждали, что в лабораториях работают только украинские граждане.
Подобные исследовательские центры США успели устроить во многих бывших советских республиках. И теперь у российских границ происходят регулярные вспышки инфекций: африканская чума — под Белгородом, кишечные расстройства — в Причерноморье. А в Дагестане впервые зафиксирована массовая гибель краснокнижных туров.